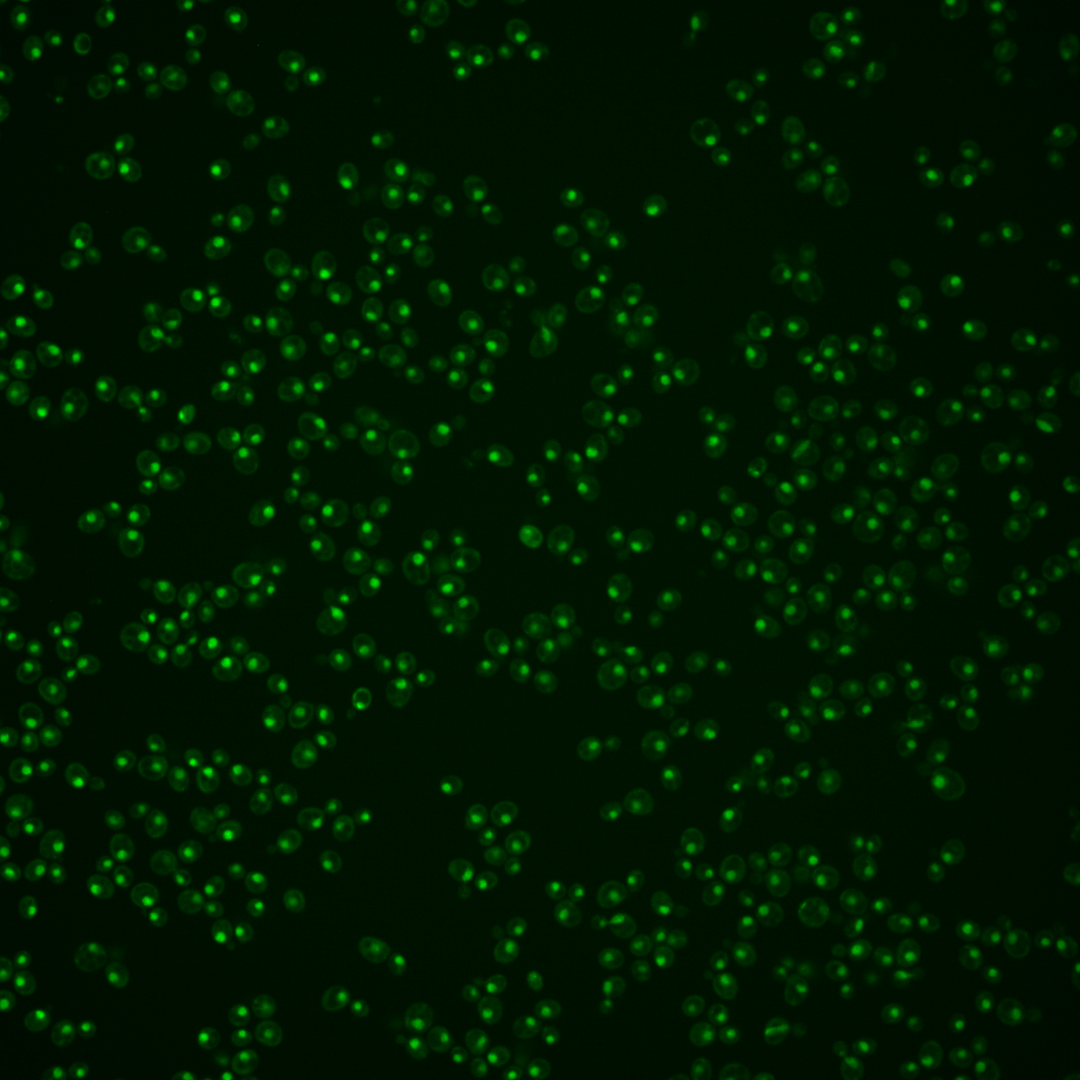
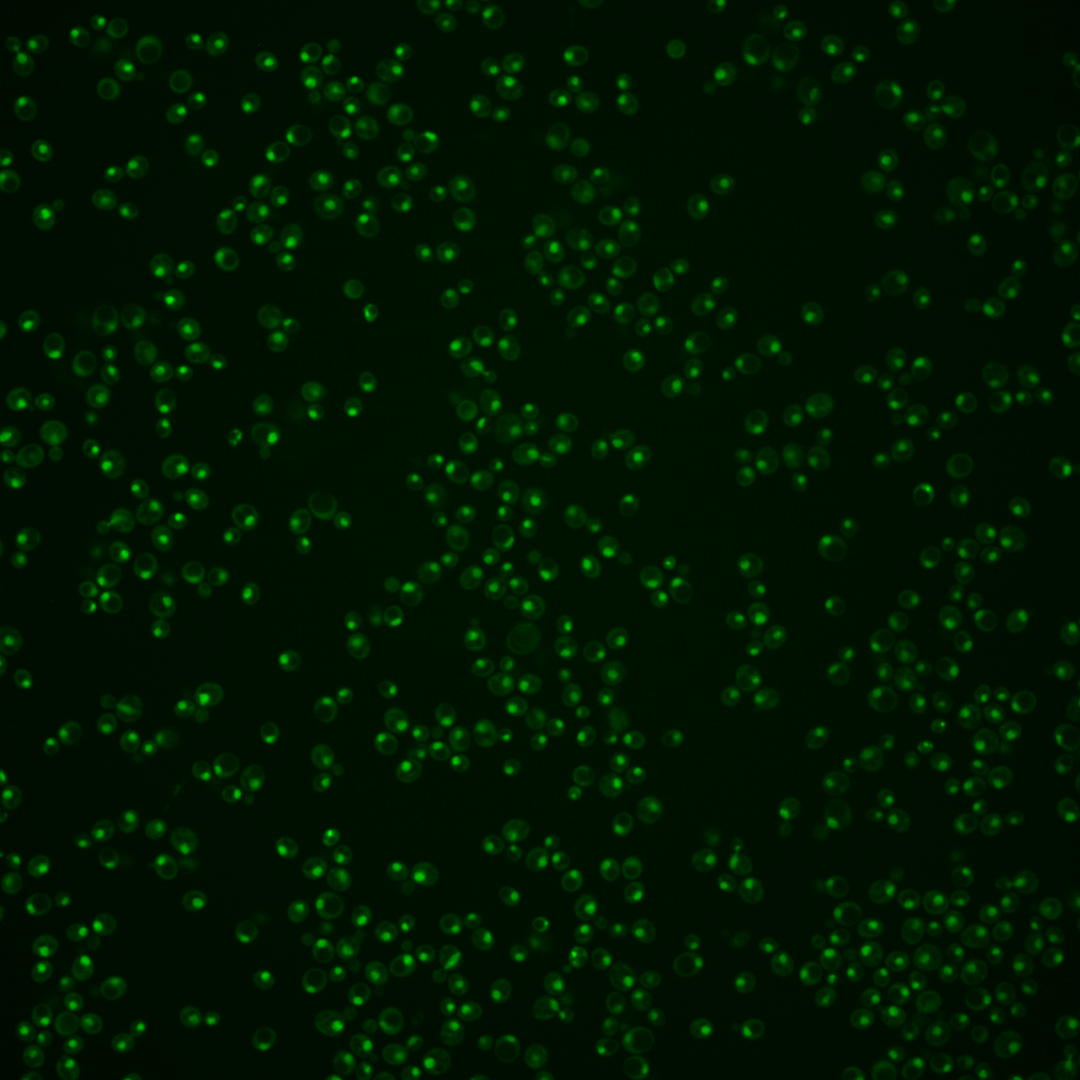
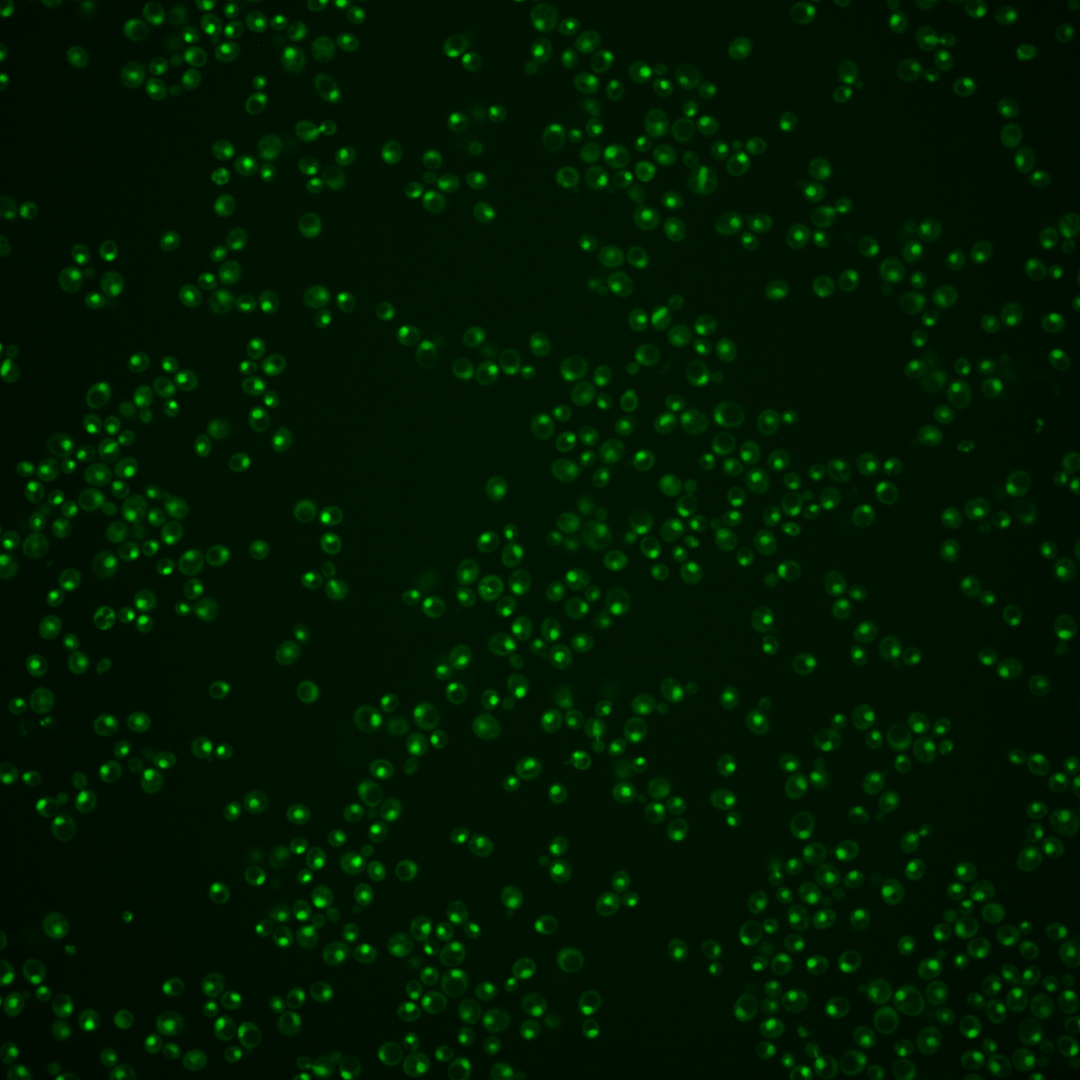
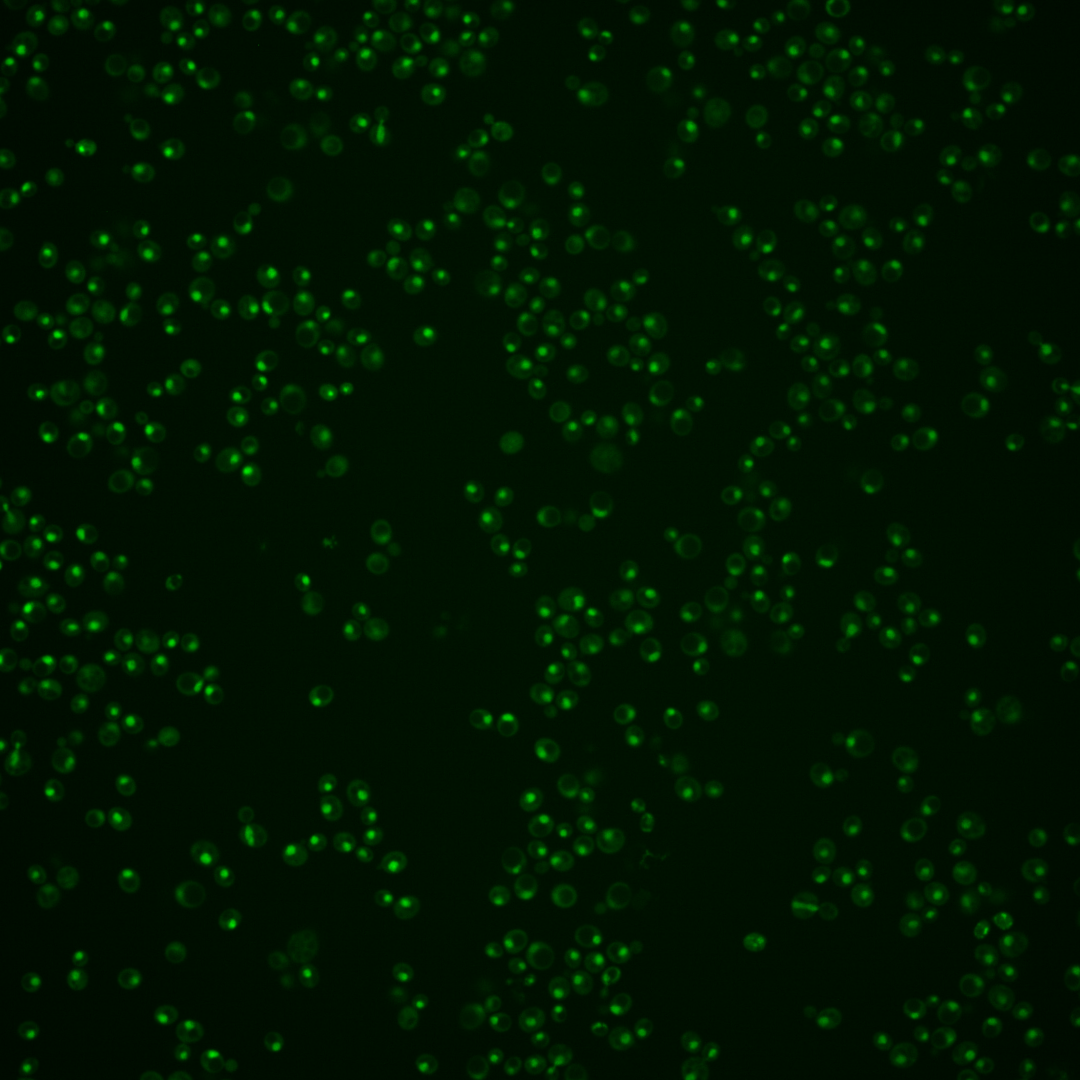

| Standard name | |
|---|---|
| Human Ortholog | |
| Description | Subunit of ISW2/yCHRAC chromatin accessibility complex; ISW2/yCHRAC also includes Itc1p, Isw2p, and Dpb4p; involved in inheritance of telomeric silencing; DLS1 has a paralog, DPB3, that arose from the whole genome duplication |
Micrographs




















































































Sub-cellular Localization
Yeast GFP Assignment
Protein Abundance
Localization Change
External localization resources
| ensLOC | DeepLoc | |||||||||||||||||||||||
|---|---|---|---|---|---|---|---|---|---|---|---|---|---|---|---|---|---|---|---|---|---|---|---|---|
| Localization | WT1 | WT2 | WT3 | RAP60 | RAP140 | RAP220 | RAP300 | RAP380 | RAP460 | RAP540 | RAP620 | RAP700 | HU80 | HU120 | HU160 | rpd3Δ_1 | rpd3Δ_2 | rpd3Δ_3 | WT1 | WT2 | WT3 | AF100 | AF140 | AF180 |
| Cortical Patches | 0 | – | – | 0 | 0 | 0 | 0 | – | 0 | 0 | 0 | 0 | – | 0 | – | 0 | 0 | 0 | 0 | 0 | 0 | 0 | 0 | 0 |
| Bud | 0 | – | – | 0 | 0 | 1 | 1 | – | 1 | 0 | 1 | 2 | – | 0 | – | 1 | 0 | 0 | 3 | 0 | 0 | 2 | 0 | 6 |
| Bud Neck | 0 | – | – | 0 | 0 | 0 | 1 | – | 0 | 0 | 0 | 2 | – | 0 | – | 0 | 0 | 0 | 0 | 0 | 0 | 0 | 1 | 0 |
| Bud Site | 1 | – | – | 0 | 0 | 4 | 2 | – | 6 | 2 | 2 | 5 | – | 0 | – | 0 | 0 | 0 | – | – | – | – | – | – |
| Cell Periphery | 0 | – | – | 0 | 0 | 0 | 0 | – | 0 | 0 | 0 | 0 | – | 0 | – | 0 | 0 | 0 | 0 | 0 | 0 | 0 | 0 | 0 |
| Cytoplasm | 5 | – | – | 15 | 20 | 9 | 6 | – | 5 | 6 | 4 | 4 | – | 1 | – | 6 | 6 | 6 | 0 | 0 | 0 | 0 | 0 | 0 |
| Endoplasmic Reticulum | 0 | – | – | 0 | 0 | 0 | 0 | – | 0 | 0 | 0 | 0 | – | 0 | – | 1 | 1 | 2 | 0 | 0 | 0 | 0 | 0 | 0 |
| Endosome | 0 | – | – | 1 | 1 | 0 | 3 | – | 0 | 0 | 0 | 0 | – | 0 | – | 2 | 3 | 1 | 1 | 0 | 0 | 0 | 0 | 2 |
| Golgi | 0 | – | – | 0 | 0 | 0 | 0 | – | 0 | 0 | 0 | 0 | – | 0 | – | 1 | 2 | 0 | 0 | 0 | 0 | 0 | 0 | 2 |
| Mitochondria | 2 | – | – | 2 | 1 | 66 | 13 | – | 61 | 34 | 43 | 57 | – | 1 | – | 3 | 3 | 7 | 0 | 0 | 0 | 0 | 0 | 1 |
| Nucleus | 181 | – | – | 238 | 319 | 291 | 505 | – | 264 | 294 | 206 | 274 | – | 19 | – | 249 | 255 | 177 | 177 | 22 | 40 | 272 | 400 | 423 |
| Nuclear Periphery | 0 | – | – | 0 | 2 | 2 | 9 | – | 2 | 1 | 1 | 6 | – | 0 | – | 1 | 1 | 0 | 0 | 0 | 0 | 0 | 0 | 0 |
| Nucleolus | 23 | – | – | 3 | 7 | 13 | 24 | – | 36 | 34 | 35 | 42 | – | 5 | – | 20 | 18 | 16 | 11 | 0 | 4 | 22 | 42 | 59 |
| Peroxisomes | 1 | – | – | 0 | 0 | 0 | 0 | – | 0 | 0 | 0 | 0 | – | 0 | – | 0 | 0 | 1 | 0 | 0 | 0 | 0 | 0 | 0 |
| SpindlePole | 1 | – | – | 4 | 2 | 1 | 10 | – | 2 | 1 | 0 | 3 | – | 0 | – | 1 | 2 | 1 | 0 | 0 | 0 | 0 | 2 | 5 |
| Vac/Vac Membrane | 3 | – | – | 2 | 4 | 0 | 4 | – | 0 | 2 | 1 | 3 | – | 0 | – | 6 | 6 | 3 | 5 | 0 | 0 | 3 | 13 | 39 |
| Unique Cell Count | 198 | 254 | 348 | 321 | 532 | 300 | 331 | 235 | 325 | 20 | 273 | 277 | 200 | 205 | 27 | 46 | 301 | 463 | 542 | |||||
| Labelled Cell Count | 217 | 265 | 356 | 387 | 578 | 377 | 374 | 293 | 398 | 26 | 291 | 297 | 214 | 205 | 27 | 46 | 301 | 463 | 542 | |||||
Yeast GFP Assignment
Protein Abundance
| Screen | WT1 | WT2 | WT3 | RAP60 | RAP140 | RAP220 | RAP300 | RAP380 | RAP460 | RAP540 | RAP620 | RAP700 | HU80 | HU120 | HU160 | rpd3Δ_1 | rpd3Δ_2 | rpd3Δ_3 | AF100 | AF140 | AF180 |
|---|---|---|---|---|---|---|---|---|---|---|---|---|---|---|---|---|---|---|---|---|---|
| Mean Cell GFP Intensity (1e-4) | 8.6 | – | – | 7.7 | 8.4 | 5.1 | 6.3 | – | 5.5 | 5.9 | 5.4 | 5.7 | – | 7.5 | – | 10.7 | 11.2 | 10.9 | 7.8 | 8.1 | 8.1 |
| Std Deviation (1e-4) | 1.8 | – | – | 1.6 | 2.1 | 1.3 | 1.2 | – | 1.2 | 1.3 | 1.1 | 1.3 | – | 1.7 | – | 2.7 | 2.5 | 2.5 | 1.7 | 1.6 | 1.7 |
| Intensity Change (Log2) | – | – | – | – | – | – | – | – | – | – | – | – | – | – | – | – | – | – | – | – | – |
Localization Change
| Localization | RAP60 | RAP140 | RAP220 | RAP300 | RAP380 | RAP460 | RAP540 | RAP620 | RAP700 | HU80 | HU120 | HU160 | rpd3Δ_1 | rpd3Δ_2 | rpd3Δ_3 |
|---|---|---|---|---|---|---|---|---|---|---|---|---|---|---|---|
| Actin | – | – | – | – | – | – | – | – | – | – | – | – | – | – | – |
| Bud | – | – | – | – | – | – | – | – | – | – | – | – | – | – | – |
| Bud Neck | – | – | – | – | – | – | – | – | – | – | – | – | – | – | – |
| Bud Site | – | – | – | – | – | – | – | – | – | – | – | – | – | – | – |
| Cell Periphery | – | – | – | – | – | – | – | – | – | – | – | – | – | – | – |
| Cyto | – | – | – | – | – | – | – | – | – | – | – | – | – | – | – |
| Endoplasmic Reticulum | – | – | – | – | – | – | – | – | – | – | – | – | – | – | – |
| Endosome | – | – | – | – | – | – | – | – | – | – | – | – | – | – | – |
| Golgi | – | – | – | – | – | – | – | – | – | – | – | – | – | – | – |
| Mitochondria | – | – | – | – | – | – | – | – | – | – | – | – | – | – | – |
| Nuclear Periphery | – | – | – | – | – | – | – | – | – | – | – | – | – | – | – |
| Nuc | – | – | – | – | – | – | – | – | – | – | – | – | – | – | – |
| Nucleolus | – | – | – | – | – | – | – | – | – | – | – | – | – | – | – |
| Peroxisomes | – | – | – | – | – | – | – | – | – | – | – | – | – | – | – |
| SpindlePole | – | – | – | – | – | – | – | – | – | – | – | – | – | – | – |
| Vac | – | – | – | – | – | – | – | – | – | – | – | – | – | – | – |
| Cortical Patches | – | – | – | – | – | – | – | – | – | – | – | – | – | – | – |
| Cytoplasm | – | – | – | – | – | – | – | – | – | – | – | – | – | – | – |
| Nucleus | – | – | – | – | – | – | – | – | – | – | – | – | – | – | – |
| Vacuole | – | – | – | – | – | – | – | – | – | – | – | – | – | – | – |
External localization resources
Images






























Protein Concentration and Protein Localization Data
| R1 | R2 | R3 | ||||||||||||||||
|---|---|---|---|---|---|---|---|---|---|---|---|---|---|---|---|---|---|---|
| G1 Pre-START | G1 Post-START | S/G2 | Metaphase | Anaphase | Telophase | G1 Pre-START | G1 Post-START | S/G2 | Metaphase | Anaphase | Telophase | G1 Pre-START | G1 Post-START | S/G2 | Metaphase | Anaphase | Telophase | |
| Concentration | 2.1804 | 1.8878 | 1.6007 | 1.5297 | 1.3371 | 1.4495 | 3.0565 | 2.8024 | 2.8653 | 2.7329 | 2.1871 | 2.8171 | 4.4517 | 4.4413 | 3.7944 | 4.1694 | 4.4331 | 4.3302 |
| Actin | 0.0263 | 0 | 0.0109 | 0.013 | 0.0136 | 0.0008 | 0.0057 | 0 | 0 | 0 | 0 | 0 | 0.0367 | 0 | 0.0135 | 0.0002 | 0.0042 | 0 |
| Bud | 0.0003 | 0 | 0.0003 | 0.0004 | 0.0004 | 0.0001 | 0.0001 | 0 | 0 | 0 | 0 | 0 | 0.0007 | 0 | 0.0003 | 0.0002 | 0.0008 | 0 |
| Bud Neck | 0.0015 | 0.0001 | 0.0016 | 0.0167 | 0.0006 | 0.0011 | 0.0003 | 0 | 0 | 0 | 0.0002 | 0.0006 | 0.0034 | 0 | 0.0006 | 0.0002 | 0.0021 | 0.0006 |
| Bud Periphery | 0.0005 | 0 | 0.0004 | 0.0008 | 0.0009 | 0.0004 | 0.0001 | 0 | 0 | 0 | 0 | 0 | 0.0017 | 0 | 0.0008 | 0.0002 | 0.0029 | 0 |
| Bud Site | 0.0017 | 0 | 0.0037 | 0.0011 | 0.0009 | 0.0004 | 0.0003 | 0 | 0 | 0 | 0 | 0 | 0.0058 | 0.0001 | 0.0011 | 0.0016 | 0.0022 | 0 |
| Cell Periphery | 0.0001 | 0 | 0.0002 | 0.0002 | 0.0001 | 0.0001 | 0 | 0 | 0 | 0 | 0 | 0 | 0.0004 | 0 | 0.0002 | 0.0002 | 0.0006 | 0 |
| Cytoplasm | 0.0012 | 0 | 0.002 | 0.0008 | 0.0004 | 0.0006 | 0.0026 | 0.0006 | 0.0001 | 0 | 0 | 0 | 0.0009 | 0 | 0.0032 | 0.0023 | 0.0205 | 0 |
| Cytoplasmic Foci | 0.0035 | 0 | 0.0026 | 0.0013 | 0.0026 | 0.0007 | 0.0059 | 0 | 0 | 0 | 0 | 0 | 0.0155 | 0 | 0.0032 | 0.0035 | 0.0138 | 0 |
| Eisosomes | 0.0002 | 0 | 0.0003 | 0.0001 | 0.0002 | 0 | 0.0005 | 0 | 0 | 0 | 0 | 0 | 0.0009 | 0 | 0.0001 | 0 | 0.0001 | 0 |
| Endoplasmic Reticulum | 0.0011 | 0 | 0.0021 | 0.0004 | 0.0012 | 0.0006 | 0.0013 | 0.0001 | 0 | 0 | 0 | 0 | 0.0007 | 0 | 0.0016 | 0.0029 | 0.003 | 0 |
| Endosome | 0.007 | 0 | 0.0055 | 0.0057 | 0.0116 | 0.004 | 0.0065 | 0.0003 | 0 | 0 | 0 | 0 | 0.0101 | 0 | 0.0062 | 0.0492 | 0.023 | 0 |
| Golgi | 0.0027 | 0 | 0.0015 | 0.0062 | 0.0052 | 0.0005 | 0.0013 | 0 | 0 | 0 | 0 | 0 | 0.0084 | 0 | 0.0017 | 0.0021 | 0.0018 | 0 |
| Lipid Particles | 0.0049 | 0 | 0.0022 | 0.0007 | 0.0113 | 0.0019 | 0.0044 | 0 | 0 | 0 | 0 | 0 | 0.011 | 0 | 0.0034 | 0.008 | 0.005 | 0 |
| Mitochondria | 0.0027 | 0.0001 | 0.0074 | 0.0039 | 0.0048 | 0.0059 | 0.0012 | 0.0001 | 0.0001 | 0 | 0.0002 | 0 | 0.0036 | 0.0001 | 0.0057 | 0.0016 | 0.0019 | 0.0001 |
| None | 0.0014 | 0 | 0.0037 | 0.0001 | 0.0012 | 0.0003 | 0.0078 | 0.0001 | 0 | 0 | 0 | 0 | 0.0012 | 0 | 0.0006 | 0.0009 | 0.0081 | 0 |
| Nuclear Periphery | 0.0076 | 0.001 | 0.0091 | 0.004 | 0.0183 | 0.0062 | 0.0071 | 0.0045 | 0.0027 | 0.0001 | 0.0004 | 0.0001 | 0.0023 | 0.0002 | 0.0084 | 0.0102 | 0.0042 | 0.0001 |
| Nucleolus | 0.0175 | 0.0134 | 0.008 | 0.013 | 0.0714 | 0.0341 | 0.0119 | 0.0123 | 0.0071 | 0.0055 | 0.0434 | 0.0407 | 0.0469 | 0.0156 | 0.0135 | 0.0109 | 0.0786 | 0.0267 |
| Nucleus | 0.9045 | 0.9849 | 0.9256 | 0.9275 | 0.8441 | 0.936 | 0.9247 | 0.973 | 0.9896 | 0.9942 | 0.9553 | 0.9575 | 0.8192 | 0.9834 | 0.9184 | 0.885 | 0.8094 | 0.9718 |
| Peroxisomes | 0.003 | 0 | 0.0008 | 0.0009 | 0.0025 | 0.0004 | 0.0032 | 0 | 0 | 0 | 0 | 0 | 0.0134 | 0 | 0.0076 | 0.0003 | 0.0017 | 0 |
| Punctate Nuclear | 0.0108 | 0.0006 | 0.0103 | 0.0012 | 0.0064 | 0.0044 | 0.0141 | 0.0081 | 0.0002 | 0.0001 | 0.0003 | 0.0009 | 0.0158 | 0.0004 | 0.0065 | 0.0017 | 0.0134 | 0.0006 |
| Vacuole | 0.0008 | 0 | 0.0009 | 0.0012 | 0.0009 | 0.0009 | 0.0005 | 0.0006 | 0.0001 | 0 | 0.0001 | 0 | 0.001 | 0 | 0.0023 | 0.0146 | 0.0023 | 0 |
| Vacuole Periphery | 0.0007 | 0 | 0.0008 | 0.0005 | 0.0014 | 0.0007 | 0.0004 | 0.0003 | 0.0001 | 0 | 0 | 0 | 0.0005 | 0 | 0.001 | 0.0044 | 0.0005 | 0 |
Sequencing Data
| R1 | R2 | |||||||||
|---|---|---|---|---|---|---|---|---|---|---|
| G1 Post-START | S/G2 | Metaphase | Anaphase | Telophase | G1 Post-START | S/G2 | Metaphase | Anaphase | Telophase | |
| Gene Expression | 33.9341 | 19.571 | 18.8792 | 26.4546 | 26.9659 | 30.6332 | 33.6399 | 34.7248 | 30.3263 | 25.0247 |
| Translational Efficiency | 0.4749 | 1.0028 | 0.9283 | 0.7354 | 0.6803 | 0.6607 | 0.6315 | 0.5976 | 0.7196 | 0.6596 |
Hit Data
| Dataset | Hit |
|---|---|
| Protein Concentration | ✘ |
| Protein Localization | ✘ |
| Gene Expression | ✘ |
| Translational Efficiency | ✘ |
Endocytosis
| Temp | Actin Patch (Sac6-tdTomato) | Cortical Patch (Sla1-GFP) | Late Endosome (Snf7-GFP) | Vacuole (Vph1-GFP) |
|---|---|---|---|---|
| 37℃ | ||||
| RT |
Cell Cycle Omics
CYCLoPs (Dls1-GFP)
| Gene / Allele | Actin Patch (Sac6-tdTomato) | Cortical Patch (Sla1-GFP) | Late Endosome (Snf7-GFP) | Vacuole (Sac6-tdTomato) |
|---|
| Gene | Images |
|---|
| Gene | Images |
|---|
Images are not yet available
Images are not yet available